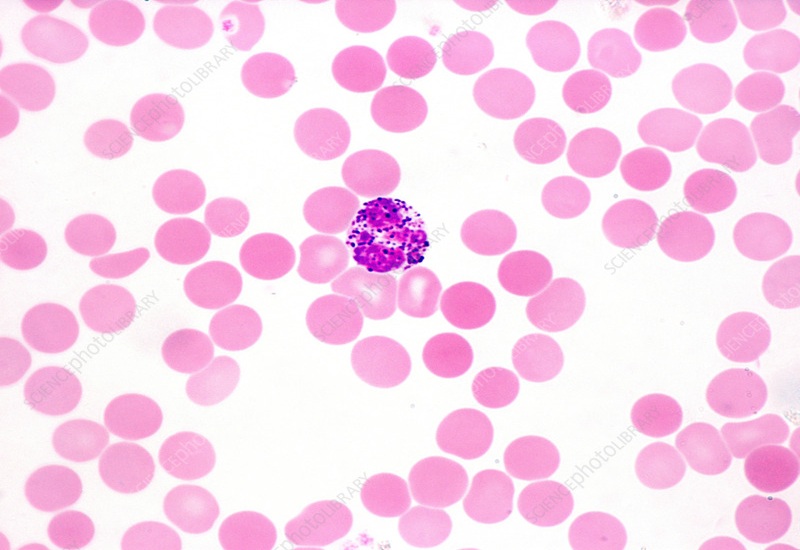

Bạch cầu ái kiềm là loại bạch cầu hiếm nhưng đóng vai trò quan trọng trong cơ chế phòng vệ của cơ thể. Chúng tham gia vào các phản ứng viêm, chống ký sinh trùng và điều chỉnh quá trình miễn dịch. Việc hiểu rõ bạch cầu ái kiềm là gì và tác động thế nào tới hệ miễn dịch sẽ giúp phát hiện sớm bất thường trong hệ miễn dịch và chăm sóc sức khỏe chủ động hơn.
Bạch cầu ái kiềm là gì?
Bạch cầu ái kiềm (Basophils) là một loại bạch cầu hiếm trong máu, chiếm khoảng 0,5–1% tổng số bạch cầu, nhưng đóng vai trò quan trọng trong hệ miễn dịch. Chúng là một phần của hệ thống miễn dịch bẩm sinh, giúp cơ thể nhận diện và phản ứng với các tác nhân lạ như vi khuẩn, virus, hoặc các chất gây dị ứng.
Bạch cầu ái kiềm chứa các hạt giàu histamine, heparin và một số cytokine. Khi cơ thể gặp phải dị nguyên hoặc mầm bệnh, bạch cầu này sẽ giải phóng các chất trên, dẫn đến phản ứng viêm tại chỗ, co mạch và tăng tính thấm mao mạch. Đây là cơ chế cơ bản giúp cơ thể chống lại tác nhân gây hại, nhưng cũng có thể là nguyên nhân gây ra các triệu chứng dị ứng như ngứa, sưng tấy, hoặc mẩn đỏ.
Ngoài vai trò trong phản ứng dị ứng, bạch cầu ái kiềm còn tham gia vào việc điều hòa quá trình viêm và hỗ trợ các tế bào miễn dịch khác hoạt động hiệu quả. Mặc dù số lượng của chúng trong máu khá thấp, nhưng bất thường về mức độ của chúng – tăng hoặc giảm – có thể là dấu hiệu cảnh báo một số bệnh lý, từ dị ứng, nhiễm trùng đến rối loạn máu hiếm gặp.
Trong thực hành xét nghiệm, bạch cầu ái kiềm được đo thông qua công thức máu toàn phần (CBC). Khi chỉ số này tăng hoặc giảm, bác sĩ sẽ kết hợp với triệu chứng lâm sàng và các xét nghiệm khác để đánh giá tình trạng sức khỏe tổng thể. Nhiều trường hợp tỷ lệ bạch cầu ái kiềm tăng là dấu hiệu sớm nhưng thường bị bỏ qua, dẫn đến chậm trễ trong chẩn đoán các rối loạn miễn dịch hoặc bệnh tăng sinh tủy.
Cấu tạo của bạch cầu ái kiềm là gì?
Bạch cầu ái kiềm là những tế bào máu có kích thước nhỏ, hình tròn hoặc hơi bầu dục, với đặc điểm dễ nhận biết là chứa nhiều hạt bắt màu basophilic (ưa kiềm) khi nhuộm tiêu bản máu. Đây chính là lý do chúng được gọi là “ái kiềm”. Cấu tạo của chúng gồm:
Nhân tế bào
Nhân của bạch cầu ái kiềm thường có hình thù không đều, thường chia thành 2–3 thuỳ, và màu nhạt khi nhuộm tiêu bản. Nhân chứa DNA và các yếu tố điều hòa, chịu trách nhiệm kiểm soát hoạt động tế bào, sản xuất các protein cần thiết và phối hợp với các tín hiệu miễn dịch khác. Sự phân thuỳ của nhân giúp tế bào linh hoạt trong quá trình di chuyển và tương tác với các tế bào miễn dịch khác.
Bào tương và các hạt đặc trưng
Bào tương chiếm phần lớn diện tích tế bào và chứa nhiều hạt ái kiềm (basophilic granules) đặc trưng. Những hạt này chứa các chất quan trọng như:
- Histamine: Khi được giải phóng, gây giãn mạch, tăng tính thấm mao mạch, dẫn đến sưng tấy, mẩn đỏ và các triệu chứng dị ứng.
- Heparin: Một chất chống đông máu tự nhiên, giúp điều hòa quá trình đông máu tại chỗ viêm.
- Proteoglycan và cytokine: Tham gia điều hòa phản ứng viêm, hướng dẫn và kích hoạt các tế bào miễn dịch khác như bạch cầu ưa eosin hoặc tế bào mast.
Các hạt này được “dự trữ” trong tế bào và chỉ được giải phóng khi có kích thích, ví dụ như khi gặp dị nguyên, vi khuẩn hoặc virus. Chính cơ chế giải phóng các hạt này làm bạch cầu ái kiềm trở thành nhân tố quan trọng trong các phản ứng miễn dịch nhanh.

Màng tế bào và thụ thể
Bạch cầu ái kiềm được bao bọc bởi màng tế bào, trên đó có nhiều thụ thể đặc hiệu như thụ thể IgE, thụ thể chemokine và các thụ thể cytokine. Những thụ thể này giúp tế bào nhận diện các tín hiệu từ môi trường hoặc từ các tế bào miễn dịch khác, quyết định xem có giải phóng hạt hay không. Đây là yếu tố quan trọng giúp nó phản ứng chính xác và kịp thời.
Vai trò của bạch cầu ái kiềm tác động tới hệ miễn dịch
Bạch cầu ái kiềm không chỉ là một con số trong xét nghiệm máu mà còn đóng vai trò quan trọng trong nhiều phản ứng miễn dịch của cơ thể. Chúng tham gia điều hòa viêm, phản ứng dị ứng, chống ký sinh trùng và thậm chí góp phần vào các cơ chế miễn dịch phức tạp khác, cụ thể:
Tham gia phản ứng dị ứng
Bạch cầu ái kiềm đóng vai trò trung tâm trong các phản ứng dị ứng tức thì. Khi cơ thể tiếp xúc lần đầu với chất gây dị ứng (dị nguyên), hệ miễn dịch sản xuất kháng thể IgE gắn lên bề mặt của chúng. Lần tiếp xúc thứ hai, dị nguyên liên kết với IgE trên tế bào, kích hoạt bạch cầu ái kiềm giải phóng các chất từ hạt.
Trong đó, histamine làm giãn mạch máu, tăng tính thấm mạch và co thắt cơ trơn, dẫn đến đỏ, sưng và khó thở. Leukotriene và prostaglandin cũng góp phần co thắt phế quản và tăng tiết chất nhầy, gây ra các triệu chứng dị ứng như hen suyễn. Nghiên cứu của Galli và cộng sự đã chứng minh rằng bạch cầu ái kiềm cùng tế bào mast là nguồn chính giải phóng các chất này trong phản ứng dị ứng nghiêm trọng.
Chống lại ký sinh trùng
Bạch cầu ái kiềm tham gia phản ứng miễn dịch chống ký sinh trùng lớn như giun. Khi ký sinh trùng xâm nhập, cơ thể sản xuất IgE, kích hoạt bạch cầu ái kiềm giải phóng histamine và các cytokine như IL-4, IL-13. Những chất này giúp tăng nhu động ruột, đẩy ký sinh trùng ra ngoài qua phân và hỗ trợ các tế bào miễn dịch khác, đặc biệt là bạch cầu ái toan, tiêu diệt ký sinh trùng.
Nghiên cứu trên chuột của Obata và cộng sự (2010) cho thấy bạch cầu ái kiềm được huy động nhanh đến vị trí nhiễm trùng và là nguồn IL-4 quan trọng ở giai đoạn đầu, giúp loại bỏ ký sinh trùng hiệu quả.

Điều hòa phản ứng miễn dịch
Bạch cầu ái kiềm không chỉ gây phản ứng dị ứng mà còn có vai trò điều hòa miễn dịch. Chúng có thể trình diện kháng nguyên cho tế bào T, giúp tế bào T biệt hóa sang kiểu TH2 thông qua IL-4 và TSLP. Điều này giúp hệ miễn dịch phản ứng hiệu quả với các tác nhân ngoại lai. Ngoài ra, bạch cầu ái kiềm còn liên quan đến việc điều chỉnh phản ứng viêm trong một số bệnh tự miễn, có thể góp phần kiểm soát hoặc làm tăng viêm tùy bối cảnh.
Các vai trò khác
Ngoài các chức năng chính, bạch cầu ái kiềm còn có những vai trò phức tạp khác. Chúng có thể tham gia giám sát miễn dịch chống ung thư, tiêu diệt một số tế bào ung thư giai đoạn đầu, mặc dù trong một số tình huống lại có thể thúc đẩy sự phát triển khối u.
Bạch cầu ái kiềm cũng liên quan đến cơ chế bệnh sinh của một số bệnh tự miễn như lupus ban đỏ hệ thống và viêm khớp dạng thấp. Hơn nữa, chúng có vai trò trong sửa chữa mô và xơ hóa, tham gia làm lành vết thương và kích hoạt fibroblast để hình thành mô mới.
Bạch cầu ái kiềm tăng khi nào?
Bạch cầu ái kiềm tăng khi nào là thắc mắc phổ biến nhất của người đọc sau khi nhận kết quả xét nghiệm. Thực tế, bạch cầu ái kiềm tăng là hiện tượng số lượng bạch cầu ái kiềm trong máu vượt mức bình thường, phản ánh cơ thể đang có các phản ứng miễn dịch đặc hiệu. Tỷ lệ bạch cầu ái kiềm tăng thường không quá cao, nhưng nếu kéo dài hoặc tăng mạnh có thể cảnh báo một số vấn đề sức khỏe.

Một số nguyên nhân khiến bạch cầu ái kiềm tăng gồm:
- Phản ứng dị ứng và viêm: Một trong những nguyên nhân phổ biến khiến bạch cầu ái kiềm tăng là các phản ứng dị ứng. Các bệnh như viêm mũi dị ứng, hen suyễn, mề đay, hoặc viêm da dị ứng khiến hệ miễn dịch kích thích sản xuất bạch cầu ái kiềm để chống lại các tác nhân gây dị ứng. Trong trường hợp này, tỷ lệ bạch cầu ái kiềm tăng thường vừa phải, nhưng vẫn đủ để bác sĩ phát hiện qua xét nghiệm máu định kỳ.
- Nhiễm ký sinh trùng hoặc vi khuẩn: Bạch cầu ái kiềm tăng cũng xuất hiện khi cơ thể bị nhiễm ký sinh trùng như giun sán hoặc một số loại vi khuẩn. Khi đó, nó tham gia vào quá trình viêm, giải phóng enzyme để tiêu diệt ký sinh trùng. Trong các trường hợp nhiễm nặng, tỷ lệ bạch cầu ái kiềm tăng có thể cao hơn mức bình thường, cảnh báo cơ thể đang trong trạng thái phản ứng miễn dịch mạnh.
- Tác dụng phụ của thuốc và yếu tố sinh lý: Một số loại thuốc, chẳng hạn như corticosteroid hoặc thuốc điều trị ung thư, có thể làm bạch cầu ái kiềm tăng. Ngoài ra, yếu tố sinh lý như thay đổi nội tiết tố hoặc căng thẳng kéo dài cũng có thể gây bạch cầu ái kiềm tăng tạm thời. Việc này thường không nguy hiểm nếu mức tăng nhẹ và thoáng qua.
- Các bệnh lý mạn tính: Trong một số bệnh lý mạn tính như viêm khớp dạng thấp hoặc một số bệnh lý huyết học, bạch cầu ái kiềm tăng kéo dài có thể là dấu hiệu cơ thể đang duy trì trạng thái viêm hoặc phản ứng miễn dịch liên tục. Tỷ lệ bạch cầu ái kiềm tăng trong trường hợp này cần được theo dõi thường xuyên để phát hiện sớm các biến chứng.
Bạch cầu ái kiềm tăng khi nào phụ thuộc vào nhiều yếu tố: Dị ứng, nhiễm trùng, tác dụng phụ của thuốc, yếu tố sinh lý hoặc bệnh lý mạn tính. Việc theo dõi tỷ lệ bạch cầu ái kiềm tăng qua xét nghiệm máu định kỳ giúp phát hiện sớm các vấn đề sức khỏe và điều chỉnh các biện pháp chăm sóc phù hợp.
Tóm lại, bạch cầu ái kiềm không chỉ là một chỉ số xét nghiệm máu mà còn đóng vai trò quan trọng trong hệ miễn dịch, tham gia vào phản ứng chống viêm, tiêu diệt vi sinh vật và điều hòa cân bằng miễn dịch. Việc hiểu rõ bạch cầu ái kiềm là gì và tác động của chúng giúp chúng ta đánh giá chính xác tình trạng sức khỏe và có những biện pháp chăm sóc phù hợp.
Nguồn tài liệu tham khảo
- Journal of Allergy and Clinical Immunology – Basophils in allergic inflammation.
- Nature Reviews Immunology – Emerging roles of basophils in immune regulation.
- American Society of Hematology – Basophilia and myeloproliferative disorders.
- World Health Organization – Classification of myeloid neoplasms.
Bài viết của: Dược sĩ Lâm Huệ Kim






